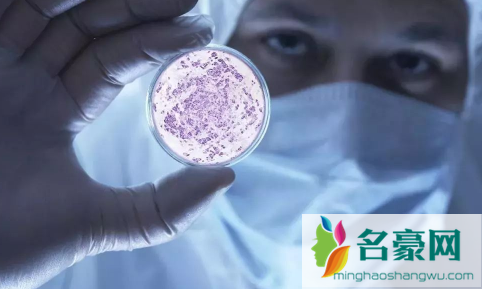

念珠菌其实就是属于真菌类病毒,也可以说是大家口中的霉菌,这种念珠菌是很喜欢在女性阴道中寄生出来,男性也会有,但是情况比较小,当性生活不卫生或者免疫力下降时可能会出现,内分泌物会出现很明显的异样。
念珠菌是什么样子图片

念珠菌是一种真菌,其形态大小因种类而异。在人体内常见的念珠菌属于酵母菌,其细胞呈圆形或卵圆形,大小在3到5微米之间。在培养基上生长时,它们形成的白色或乳白色的粘液状物质常常被比作奶酪。不同的念珠菌种类在形态上有所不同,有些种类可能形成类似丝状的菌丝。
怎么确定念珠菌痊愈了
要确定念珠菌感染已经痊愈,需要进行复查。通常情况下,医生会建议在完成治疗后再进行复查,以确保病情已经得到控制。
对于女性念珠菌感染,常见的复查方式是通过分泌物检测或者阴道分泌物培养来确定是否痊愈。对于口腔念珠菌感染,可以通过口腔刮片检查来确定是否痊愈。对于耳念珠菌感染,则需要再次进行耳朵检查。
如果复查结果显示感染已经得到控制,即可确定念珠菌感染已经痊愈。但需要注意的是,为了避免再次感染,建议保持良好的卫生习惯,并定期进行体检。
念珠菌怎么才能治断根

念珠菌感染的治疗需要根据具体情况进行,一般包括药物治疗和预防复发的措施。对于局部症状比较轻的念珠菌感染,如口腔念珠菌、皮肤念珠菌等,一般采用外用药物或口服抗真菌药物治疗。而对于严重的或反复发作的念珠菌感染,可能需要更强效的药物治疗,包括静脉注射抗真菌药物等。此外,预防复发的措施也非常重要,如保持局部卫生、避免使用含糖的药物或化妆品、调节免疫功能等。综合治疗可以更好地控制念珠菌感染,并避免复发。
转载请注明出处。
相关文章







精彩导读
热门资讯